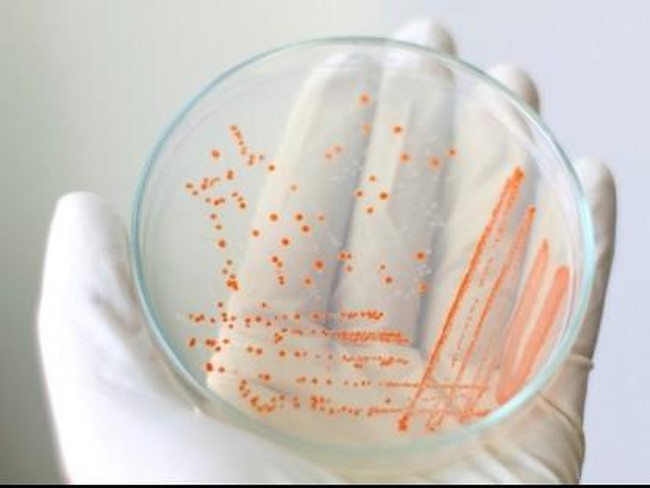
5 Benda Sehari-hari yang Bisa Jadi Sarang Bakteri

Apa saja contohnya? Dikutip dari berbagai sumber, berikut beberapa benda tersebut:
Baca juga: Sabun Pencuci Tangan Vs Sabun Batangan, Mana Lebih Baik untuk Cuci Tangan?
1. Layar ponsel
|
Foto: thinkstock
|
Pakar mikrobiologi molekuler, Simon Park, mengungkap Kebanyakan bakteri yang tinggal di handphone adalah bakteri yang tidak berbahaya seperti bakteri Micrococcus.
Ditemukan pula bakteri Staphylococcus aureus yang pada kondisi tertentu bisa menyebabkan infeksi. Staphylococcus aureus diasosiasikan dengan beberapa kondisi patologi, seperti bisul, jerawat, pneumonia, meningitis, dan arthritits.
2. Spons cuci piring
|
Foto: dok. Thinkstock
|
Pesan penting: Biasakan untuk tidak merendam spons di air sabun setelah selesai digunakan. Peras dan keringkan spons setiap hari. Jangan lupa untuk menggantinya dengan yang baru secara rutin. Untuk kain dapur, usahakan untuk mencucinya paling tidak tiga hari sekali.
3. Bantal
|
Foto: thinkstock
|
Cliff Bassett, MD, pendiri sekaligus direktur Allergy and Asthma Care of New York mengatakan agar alergen, debu, dan kuman bisa hilang dengan optimal, rendam seprai lengkap dengan sarung bantal-guling serta selimut dengan air hangat sebelum mencucinya dengan sabun.
4. Sikat gigi
|
Foto: Getty Images
|
"Salah satu bakteri di bulu sikat gigi ini ada yang sama seperti di kotoran manusia. Bakteri memfermentasi sisa-sisa makanan di mulut dan menghasilkan asam yang merusak gigi," kata drg Melanie.
5. Handuk
|
Foto: thinkstock
|
Studi yang dilakukan oleh peneliti di University of Arizona pada tahun 2013 melihat bahwa 25,6 persen handuk bisa menyimpan bakteri Escherichia coli yang berkaitan dengan kasus keracunan makanan dan diare. Pakar kesehatan dan kebersihan rumah, Maeve Richmond, merekomendasikan sebaiknya handuk diganti setiap selesai dipakai 3-4 kali.
Baca juga: Bisa Jadi Sarang Bakteri, Handuk Sebaiknya Rutin Dicuci dan Diganti
Halaman 2 dari 6